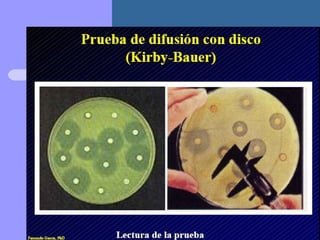
Presentación metodo de kirby bauer

Incrustar presentación
Descargado 130 veces


















El documento describe un método para determinar la sensibilidad de bacterias a antibióticos mediante la medición del diámetro de la zona de inhibición alrededor de un disco de papel impregnado con un antibiótico. El método de Kirby-Bauer, o prueba de difusión en disco, es un método simplificado que proporciona un resultado semi-cuantitativo e interpretativo sobre la concentración mínima inhibitoria de un antibiótico.